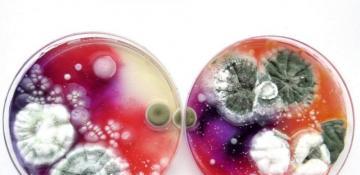
Scientists have proposed using mold to treat wounds

- News
- 12 October 2025
12 October 2025
-
Fifteen people were injured in a traffic accident in the Mazıdağ district of Mardin province, southeastern Türkiye.13 Oct 2025-05:35
-
-
The crisis has destroyed over 16,000 homes and triggered widespread power outages.13 Oct 2025-05:02
-
-
Saleh Aljafarawi, a well-known Palestinian journalist, was fatally shot in Gaza City on Saturday, just days after a Gaza ceasefire agreement was announced.13 Oct 2025-04:32
-
-
Researchers from the University of Utah have discovered that the soil mold Marquandomyces marquandii is capable of forming a unique hydrogel that could potentially replace human soft tissue.13 Oct 2025-04:00
-
-
-
-
Israel still faces security challenges, as some of its enemies try to rebuild to attack again.13 Oct 2025-02:30
-
-
On October 9, Israel and Hamas reached an agreement on the initial phase of President Donald Trump’s peace plan.13 Oct 2025-01:55
-
-
A magnitude 5.7 earthquake was recorded off the coast of the Philippines.13 Oct 2025-01:25
-
-
-
-